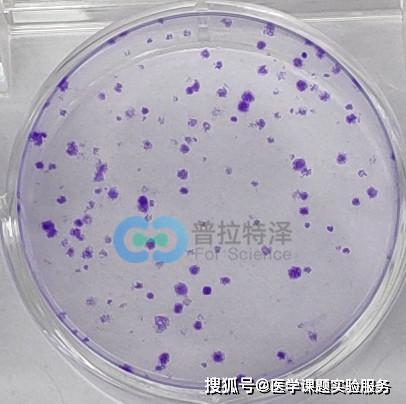
細(xì)胞檢測的方法有哪些

一、MTT比色:
MTT比色是一種目前被廣泛采用的檢測細(xì)胞生長和存活的方法,其原理是外源性MTT(四唑鹽)可被活細(xì)胞線粒體中的琥珀酸脫氫酶還原成難溶的藍(lán)紫色結(jié)晶物并沉淀在細(xì)胞中,而死細(xì)胞無此功能,DMSO(二甲基亞砜)能溶解細(xì)胞中的紫色結(jié)晶物,用酶聯(lián)檢測儀在490nm波長處檢測其光密度值,可間接反映活細(xì)胞數(shù)量。在一定范圍內(nèi),MTT結(jié)晶物形成的量與細(xì)胞數(shù)成正比,此方法已廣泛用于檢測細(xì)胞活力、觀察細(xì)胞生長等方面,具有靈敏度高、重復(fù)性好、操作簡便、經(jīng)濟(jì)、快速、易自動化、無放射性污染等特點(diǎn),與細(xì)胞計數(shù)有良好的相關(guān)性。
二、rdU標(biāo)記法
1.細(xì)胞以1.5*105/ml細(xì)胞數(shù)接種于直徑35ml培養(yǎng)皿中(內(nèi)放置一蓋玻片),培養(yǎng)1天,用含0.4% FCS培養(yǎng)液同步化3天,使絕大多數(shù)細(xì)胞處于G0期。
2.終止細(xì)胞培養(yǎng)前,加入BrdU(終濃度為30μg/L),37℃,孵育40min。
3.棄培養(yǎng)液,玻片用PBS洗滌3次。
4.甲醇/醋酸固定10min。
5.經(jīng)固定的玻片空氣干燥,0.3%H2O2-甲醇30min滅活內(nèi)源性氧化酶。
6.5%正常兔血清封閉。
7.甲酰胺100℃,5min變性核酸。
8.冰浴冷卻后PBS洗滌,加1抗即抗小鼠BrdU單抗(工作濃度1:50),陰性對照加PBS或血清。
9.按ABC法進(jìn)行檢測,蘇木素或伊紅襯染,在顯微鏡下隨機(jī)計數(shù)10個高倍視野中細(xì)胞總數(shù)及BrdU陽性細(xì)胞數(shù),計算標(biāo)記指數(shù)(LI)。
三、結(jié)晶紫法
1.體外細(xì)胞培養(yǎng)結(jié)束后,去培養(yǎng)液,加入11%的戊二醛固定,置于振蕩器上搖20min。
2.固定細(xì)胞用去離子水洗滌至戊二醛液洗凈。
3.置空氣或烘箱37℃徹底干燥。
4.加入0.1%的結(jié)晶紫液對細(xì)胞染色,振搖30min。
5.用蒸餾水洗滌,至多余的結(jié)晶紫液沖洗干凈。
6.置空氣或37℃烘箱中徹底干燥。
7.加入10%的乙酸對細(xì)胞吸收的結(jié)晶紫進(jìn)行提取。
8.1h后在酶標(biāo)儀上測定光吸收度,波長595nm。
四、酸性磷酸酶法
1.96孔細(xì)胞培養(yǎng)板中培養(yǎng)細(xì)胞,去培養(yǎng)液。用0.01mol/L PBS洗滌1次(如為懸浮細(xì)胞則用離心洗滌)。
2.去洗滌液后加入磷酸酶底物100μl/孔。
3.37℃,孵育1~4h。
4.加入0.1mol/L氫氧化鈉10μl/孔。
5.在多孔酶標(biāo)儀上405nm處測光吸收度,將細(xì)胞培養(yǎng)板其中不含細(xì)胞,同樣處理過的一孔作為空白對照,所測的每孔光吸收度可間接反應(yīng)每孔中的細(xì)胞數(shù)。如在同樣條件下作一細(xì)胞數(shù)的系列標(biāo)準(zhǔn)對照,以細(xì)胞數(shù)為X軸,光吸收度為Y軸,可作直線回歸,可推算出每孔中的細(xì)胞。
細(xì)胞免疫(CMⅠ)是由多種細(xì)胞相互作用的結(jié)果。
免疫細(xì)胞間相互作用導(dǎo)致多種細(xì)胞因子的釋放。因此細(xì)胞功能測定不僅涉及T細(xì)胞的數(shù)量和功能與包括各類因子活性測定,因此評價機(jī)體的細(xì)胞免疫功能不僅程序復(fù)雜,且很難標(biāo)準(zhǔn)化。
一、遲發(fā)型過敏反應(yīng)的體外檢測方法皮膚試驗和接觸性過敏的誘發(fā)是檢測遲發(fā)型過敏反應(yīng)(DTH)的兩種常用方法。皮膚試驗中誘發(fā)對曾經(jīng)使病人致敏的抗原的再次應(yīng)答,而接觸性過敏是測試受者對從未接觸過的物質(zhì)發(fā)生致敏的能力。
1.皮膚試驗 用皮膚試驗診斷DTH,常用的抗原有結(jié)核菌純蛋白衍生物(PPD)、腮腺炎病毒、念珠菌素等,在人類試驗時在前臂皮內(nèi)注射少量可溶性抗原,24~48小后,測量紅腫硬結(jié)的大小,硬結(jié)直徑大于10mm即被看作為陽性。表明受試者對該病原菌有了一定的細(xì)胞免疫能力,若皮試無反應(yīng),可用更高濃度的抗原重復(fù)試驗,若仍無反應(yīng)即為陰性,需排除皮試技術(shù)誤差,也可能受試者從未接觸過此抗原,也可能由于細(xì)胞免疫功能缺損,或由于細(xì)胞免疫功能缺損,或由于嚴(yán)重感染(麻疹、慢性播散性結(jié)核)造成的無反應(yīng)性。
2.接觸性過敏常應(yīng)用低分子量化合物如二硝基氯苯(DNCB)誘生接觸性過敏?;衔锱c皮膚蛋白質(zhì)結(jié)合而導(dǎo)至DTH反應(yīng)。
在動物試驗時,初次皮膚上涂抹DNCB后間隔7~10天再激發(fā)刺激,則皮膚出現(xiàn)即為陽性。此試驗人類已不使用。
二、細(xì)胞免疫的體外檢測方法體外檢測淋巴細(xì)胞的數(shù)量和功能,最易采集的是血標(biāo)本,首先需分離或純化淋巴細(xì)胞,一般使用萄聚糖-泛影葡胺配成比重為1.077的淋巴細(xì)胞分層液,當(dāng)將血液重疊于淋巴細(xì)胞分層液之上離心時,由于紅細(xì)胞(1.092)、多形核白細(xì)胞(1.090)、淋巴細(xì)胞(1.070)的比重不同而相互分開。淋巴細(xì)胞和單核細(xì)胞在血漿和分層液交界處形成一薄層。
仔細(xì)分出這一薄層的細(xì)胞,其中淋巴細(xì)胞占80%,單核細(xì)胞占20%,淋巴細(xì)胞中T細(xì)胞占80%,B細(xì)胞占4%~10%,其作為非DT、非B細(xì)胞。1.T細(xì)胞計數(shù)(1)E花環(huán)法:人類T細(xì)胞表面有SRBC受體(CD2)能與SRBC結(jié)合形成玫瑰花環(huán)樣結(jié)構(gòu),將經(jīng)分層液分離現(xiàn)的RBM懸液與SRBC在含有血清的平衡鹽水中混合,經(jīng)37℃培養(yǎng)5~10分鐘放4℃過夜,取細(xì)胞懸計數(shù),外周血淋巴細(xì)胞中約70%~80%淋巴細(xì)胞結(jié)成花環(huán)即為T細(xì)胞。
目前此方法已用來分離T細(xì)胞,而不用做T細(xì)胞計數(shù)。(2)用單克隆抗體計數(shù)T細(xì)胞:將人的PBM分成三等份,分別用小鼠抗人CD3、CD4和CD8的單克隆抗體作第一抗體與細(xì)胞結(jié)合,再用FITC標(biāo)記的兔抗小鼠IgG抗體作第二抗體進(jìn)行間接免疫熒光染色,在熒光顯微鏡下或流式細(xì)胞儀檢測結(jié)果,在PBM中被CD3抗體染上熒光的細(xì)胞稱為CD3 細(xì)胞即總T細(xì)胞。
正常人在PBM中T細(xì)胞占70%~80%。正常人的CD4 細(xì)胞和CD8 細(xì)胞之和應(yīng)與CD3 細(xì)胞數(shù)一致。
CD4 細(xì)胞與CD8 細(xì)胞的比值正常人約為2/1而艾滋病患者則比值小于1.7。2.T細(xì)胞活化試驗 T細(xì)胞能被非特異的物質(zhì)稱為有絲分裂原所激活而向淋巴母細(xì)胞轉(zhuǎn)化。
T細(xì)胞轉(zhuǎn)化過程可伴隨有DNA、RNA、蛋白質(zhì)的合成增加,最圖導(dǎo)致細(xì)胞分裂。在光學(xué)顯微鏡下可計數(shù)轉(zhuǎn)化后的淋巴細(xì)胞數(shù),也可用氚標(biāo)記的胸腺嘧啶核苷(3HTdR)摻入正在分裂的淋巴細(xì)胞,用液閃測定儀檢查摻入正在分裂的淋巴細(xì)胞,用液測量儀檢查摻入的3H-TdR的多少確定淋巴細(xì)胞轉(zhuǎn)化率。
最近有一種不用同位素,又可用儀器測量的淋巴細(xì)胞增殖反應(yīng)的檢查法,稱為MTT檢測法,MTT是一種甲氮唑鹽,它是細(xì)胞線粒體脫氫酶的底物,細(xì)胞內(nèi)的酶可將MTT分解產(chǎn)生藍(lán)黑色甲(fromazan)產(chǎn)物。該產(chǎn)物的多少與活性細(xì)胞數(shù)正相關(guān)。
結(jié)果可用酶標(biāo)檢測儀(595mm)測量匯豐銀行密度,做為MTT法的檢查指標(biāo)。此法的結(jié)果與3H-TdR摻入法平行,并能反應(yīng)試驗中的活細(xì)胞數(shù)。
3.細(xì)胞毒試驗 TC細(xì)胞、NK細(xì)胞、LAK細(xì)胞、TIL細(xì)胞對其靶細(xì)胞有直接的細(xì)胞毒(殺傷)作用。常用的栓測細(xì)胞毒效應(yīng)的方法是51Cr-Na2Cro4鹽水溶液與靶細(xì)胞胞混合,于37℃培養(yǎng)1小時左右,51Cr即可進(jìn)入靶細(xì)胞,與胞漿蛋白結(jié)合,洗去游離的51Cr后,即可得到51Cr標(biāo)記的靶細(xì)胞,將待檢細(xì)胞毒性的細(xì)胞與51Cr標(biāo)記的靶細(xì)胞混合(比例約為50:1或100:1)靶細(xì)胞被殺傷越多,釋放到上清液中的液游離的51Cr越多,且不能被其他細(xì)胞吸收。
用γ射線測量儀檢測上清液中的cpm值,即可計算出待檢細(xì)胞殺傷活性的高低。細(xì)胞毒試驗檢測Tc細(xì)胞效應(yīng)功能是否健全,及經(jīng)IgG介導(dǎo)的ADCC效應(yīng),或NK細(xì)胞在抗腫瘤免疫中的作用是有意義的。
4.混合淋巴細(xì)胞的反應(yīng)(MIR) 是體外研究T細(xì)胞的較好的方法,雙向MLR常被用來篩選骨髓移植的供體。來自不同供體的淋巴細(xì)胞分別與病人的淋巴細(xì)胞混合培養(yǎng)4~5天,在最后8小時摻入51TdR摻入法測T細(xì)胞的反應(yīng)性。
或用細(xì)胞毒法觀察受刺激的T細(xì)胞與活的靶細(xì)胞混合(靶細(xì)胞來自與刺激細(xì)胞相同的個體)如果T細(xì)胞受刺激后產(chǎn)生了細(xì)胞毒T細(xì)胞,可殺死活的細(xì)胞,根據(jù)靶細(xì)胞釋放51Cr的多少算出T細(xì)胞移動抑制因子)和LIF(白細(xì)胞移動抑制因子)來評估細(xì)胞免疫功能。近年來應(yīng)用測定IL-2的免疫酶技術(shù),操作簡單,并能定量以取代了MIF和LIF的測定。
單個核細(xì)胞與分裂原。
一、形態(tài)學(xué)觀察方法 1、HE染色、光鏡觀察:凋亡細(xì)胞呈圓形,胞核深染,胞質(zhì)濃縮,染色質(zhì)成團(tuán)塊狀,細(xì)胞表面有“出芽”現(xiàn)象。
2、丫啶橙(AO)染色,熒光顯微鏡觀察:活細(xì)胞核呈黃綠色熒光,胞質(zhì)呈紅色熒光。凋亡細(xì)胞核染色質(zhì)呈黃綠色濃聚在核膜內(nèi)側(cè),可見細(xì)胞膜呈泡狀膨出及凋亡小體。
3、臺盼藍(lán)染色:如果細(xì)胞膜不完整、破裂,臺盼藍(lán)染料進(jìn)入細(xì)胞,細(xì)胞變藍(lán),即為壞死。如果細(xì)胞膜完整,細(xì)胞不為臺盼藍(lán)染色,則為正常細(xì)胞或凋亡細(xì)胞。
此方法對反映細(xì)胞膜的完整性,區(qū)別壞死細(xì)胞有一定的幫助。 4、透射電鏡觀察:可見凋亡細(xì)胞表面微絨毛消失,核染色質(zhì)固縮、邊集,常呈新月形,核膜皺褶,胞質(zhì)緊實,細(xì)胞器集中,胞膜起泡或出“芽”及凋亡小體和凋亡小體被臨近巨噬細(xì)胞吞噬現(xiàn)象。
二、DNA凝膠電泳 (一)檢測原理 細(xì)胞發(fā)生凋亡或壞死,其細(xì)胞DNA均發(fā)生斷裂,細(xì)胞內(nèi)小分子量DNA片斷增加,高分子DNA減少,胞質(zhì)內(nèi)出現(xiàn)DNA片斷。但凋亡細(xì)胞DNA斷裂點(diǎn)均有規(guī)律的發(fā)生在核小體之間,出現(xiàn)180-200bpDNA片斷,而壞死細(xì)胞的DNA斷裂點(diǎn)為無特征的雜亂片斷,利用此特征可以確定群體細(xì)胞的死亡,并可與壞死細(xì)胞區(qū)別。
(二)結(jié)果判斷 正?;罴?xì)胞DNA 電泳出現(xiàn)階梯狀(LADDER)條帶;壞死細(xì)胞DNA電泳類似血抹片時的連續(xù)性條帶。 三、酶聯(lián)免疫吸附法(ELISA)核小體測定 凋亡細(xì)胞的DNA斷裂使細(xì)胞質(zhì)內(nèi)出現(xiàn)核小體。
核小體由組蛋白及其伴隨的DNA片斷組成,可由ELISA法檢測。 (一)檢測步驟 1、將凋亡細(xì)胞裂解后高速離心,其上清液中含有核小體; 2、在微定量板上吸附組蛋白體; 3、加上清夜使抗組蛋白抗體與核小體上的組蛋白結(jié)合; 4、加辣過氧化物酶標(biāo)記的抗DNA抗體使之與核小體上的DNA結(jié)合; 5、加酶的底物,測光吸收制。
(二)用途 該法敏感性高,可檢測5*100/ml凋亡細(xì)胞。可用于人、大鼠、小鼠的凋亡檢測。
該法不需要特殊儀器,適合基層工作,但是不能精確測定凋亡細(xì)胞發(fā)生的絕多對量。 四、流式細(xì)胞儀分析 (一)檢測原理 細(xì)胞發(fā)生凋亡時,其細(xì)胞膜的通透性也增加,但是其程度介于正常細(xì)胞與壞死細(xì)胞之間。
利用一特點(diǎn),被檢測細(xì)胞懸液用熒光素染色,利用流式細(xì)胞儀測量細(xì)胞懸液中細(xì)胞熒光強(qiáng)度來區(qū)分正常細(xì)胞、壞死細(xì)胞核凋亡細(xì)胞。 (二)應(yīng)用價值 流式細(xì)胞儀檢測具有以下特點(diǎn): 1)、檢測的細(xì)胞數(shù)量大,因此其反映群體細(xì)胞的凋亡狀態(tài)比較準(zhǔn)確 2)、可以做許多相關(guān)性分析 3)、結(jié)合被檢測細(xì)胞的DNA含量的分析,可確定凋亡的細(xì)胞所處的細(xì)胞周期 ■檢測形態(tài)學(xué)及細(xì)胞膜完整性的Hoechs-PI雙染色法 細(xì)胞發(fā)生凋亡時,其細(xì)胞膜的通透性液增加,但其程度介于正常細(xì)胞和壞死細(xì)胞之間,利用這一特點(diǎn),被檢測細(xì)胞懸液用熒光素染色,利用流式細(xì)胞儀檢測細(xì)胞懸液中細(xì)胞熒光強(qiáng)度來區(qū)分正常細(xì)胞、壞死細(xì)胞和凋亡細(xì)胞。
利用Hoechs-PI染色法,正常細(xì)胞對染料有抗拒性,熒光染色很淺,凋亡細(xì)胞主要攝取Hoecha染料,呈現(xiàn)強(qiáng)藍(lán)色熒光,而壞死細(xì)胞主要攝取碘化丙啶(PI)而呈強(qiáng)的紅色熒光。 ■DNA片斷原位標(biāo)記法 凋亡細(xì)胞DNA片斷原位末端檢測技術(shù)是指在細(xì)胞(或組織)結(jié)構(gòu)保持不變的情況下,用熒光素、地高辛或生物素標(biāo)記的脫氧尿三磷酸(deoxyuridinetriphate,DUTP)和末端脫氧核苷酸轉(zhuǎn)移酶(TdT)相反應(yīng)與凋亡細(xì)胞裂解后3.的羥基(-OH)端結(jié)合,經(jīng)顯色反應(yīng)后檢測DNA裂解點(diǎn)的技術(shù)。
DNA片段原位標(biāo)記法有二種: 1、原位缺口轉(zhuǎn)移(in situ nick-translation,ISNT)技術(shù),它是利用DNA多聚酶I將標(biāo)記的核苷酸連接到斷裂DNA的3-OH端 2、原位缺口末端標(biāo)記技術(shù)(in situ end labelling technique,ISEL),即TUNEL法,它是利用TdT將標(biāo)記的DUPT接到3-OH端。研究證明,TUNEL法的敏感性遠(yuǎn)高于ISNT,尤其對早期凋亡的檢測,TUNEL為合適。
■檢測細(xì)胞膜成分變化的Annexin V 聯(lián)合PI法 1、原理:在細(xì)胞凋亡早期位于細(xì)胞膜內(nèi)側(cè)的磷脂酰絲氨酸(PS)遷移至細(xì)胞膜外測。磷脂結(jié)合蛋白V(Annexin V)是鈣依賴性的磷脂結(jié)合蛋白,它于PS具有高度的結(jié)合力。
因此,Annexin V可以作為探針檢測暴露在細(xì)胞外測的磷脂酰絲氨酸。故利用對PS有高度親和力的Annexin V,將Annexin V標(biāo)記上熒光素(如異硫氰酸熒光素FITC),同時結(jié)合使用PI拒染法(因壞死細(xì)胞PS亦暴露于細(xì)胞膜外測,且對PI高染)進(jìn)行凋亡細(xì)胞雙染法后用流式細(xì)胞儀即可檢測凋亡細(xì)胞。
2、結(jié)果判斷:正?;罴?xì)胞Annexin V 、PI均低染;凋亡細(xì)胞Annexin V高染、PI低染;壞死細(xì)胞Annexin V/PI均高染。 3、應(yīng)用價值:細(xì)胞發(fā)生凋亡時,膜上的PS外露早于DNA斷裂發(fā)生,因此Annexin V聯(lián)合PI染色法檢測早期細(xì)胞凋亡較TUNEL法更為靈敏。
又Annexin V聯(lián)合PI染色不需固定細(xì)胞,可避免PI染色因固定造成的細(xì)胞碎片過多及TUNEL法因固定出現(xiàn)的DNA片段丟失。因此,Annexin V聯(lián)合PI法更加省時,結(jié)果更為可靠,是最為理想的檢測細(xì)胞凋亡的方法。
根據(jù)每個細(xì)胞有一定的重量而設(shè)計的。
它可以用于單細(xì)胞、多細(xì)胞以及絲狀體微生物生長的測定。將一定體積的樣品通過離心或過濾將菌體分離出來,經(jīng)洗滌,再離心后直接稱重,求出濕重,如果是絲狀體微生物,過濾后用濾紙吸去菌絲之間的自由水,再稱重求出濕重。
不論是細(xì)菌樣品還是絲狀菌樣品,可以將它們放在已知重量的平皿或燒杯內(nèi),于105℃烘干至恒重,取出放入干燥器內(nèi)冷卻,再稱量,求出微生物干重。如果要測定固體培養(yǎng)基上生長的放線菌或絲狀真菌,可先加熱至50℃,使瓊脂熔化,過濾得菌絲體,再用50℃的生理鹽水洗滌菌絲,然后按上述方法求出菌絲體的濕重或干重。
除了干重、濕重反映細(xì)胞物質(zhì)重量外,還可以通過測定細(xì)胞中蛋白質(zhì)或DNA的含量反映細(xì)胞物質(zhì)的量。蛋白質(zhì)是細(xì)胞的主要成分,含量也比較穩(wěn)定,其中氮是蛋白質(zhì)的重要組成元素。
從一定體積的樣品中分離出細(xì)胞,洗滌后,按凱氏定氮法測出總氮量。蛋白質(zhì)含氮量為16%,細(xì)菌中蛋白質(zhì)含量占細(xì)菌固形物的50%一80%,一般以65%為代表,有些細(xì)菌則只占13%一14%,這種變化是由菌齡和培養(yǎng)條件不同所產(chǎn)生的。
因此總含氮量與蛋白質(zhì)總量之間的關(guān)系可按下列公式計算:蛋白質(zhì)總量=含氮量*6.25核酸DNA是微生物的重要遺傳物質(zhì),每個細(xì)菌的DNA含量相當(dāng)恒定,平均為8.4*`10^(-5)`NG。因此從一定體積的細(xì)菌懸液中所含的細(xì)菌中提取DNA,求得DNA含量,再計算出這一定體積的細(xì)菌懸液所含的細(xì)菌總數(shù)。
免疫學(xué)檢測方法可分為體液免疫和細(xì)胞免疫。
體液免疫:
所謂體液免疫,即以B細(xì)胞產(chǎn)生抗體來達(dá)到保護(hù)目的的免疫機(jī)制。負(fù)責(zé)體液免疫的細(xì)胞是B細(xì)胞。體液免疫的抗原多為相對分子質(zhì)量在10,000以上的蛋白質(zhì)和多糖大分子,病毒顆粒和細(xì)菌表面都帶有不同的抗原,所以都能引起體液免疫。
臨床上一個反復(fù)發(fā)作的化膿感染,常使醫(yī)生想到患者是否有免疫缺陷病,一般原發(fā)免疫缺陷發(fā)病年齡很小,而繼發(fā)免疫缺陷病人多在30歲以上。絕大多數(shù)免疫缺陷病人多表現(xiàn)為體液和細(xì)胞免疫同時受損,所以應(yīng)全面檢查這兩方面的功能。遺憾的是,目前應(yīng)用的檢測方法的局限性,其結(jié)果常難以得出明確結(jié)論。
細(xì)胞免疫:
T細(xì)胞受到抗原刺激后,增殖、分化、轉(zhuǎn)化為致敏T細(xì)胞(也叫效應(yīng)T細(xì)胞),當(dāng)相同抗原再次進(jìn)入機(jī)體的細(xì)胞中時,致敏T細(xì)胞(效應(yīng)T細(xì)胞)對抗原的直接殺傷作用及致敏T細(xì)胞所釋放的細(xì)胞因子的協(xié)同殺傷作用,統(tǒng)稱為細(xì)胞免疫。
在抗感染免疫中,細(xì)胞免疫主要參與對胞內(nèi)寄生的病原微生物的免疫應(yīng)答及對腫瘤細(xì)胞的免疫應(yīng)答,參與遲發(fā)型變態(tài)反應(yīng)和自身免疫病的形成,參與移植排斥反應(yīng)及對體液免疫的調(diào)節(jié)。也可以說,在抗感染免疫中,細(xì)胞免疫既是抗感染免疫的主要力量,參與免疫防護(hù);又是導(dǎo)致免疫病理的重要因素。
1 光學(xué)顯微鏡和倒置顯微鏡
(1) 未染色細(xì)胞:凋亡細(xì)胞的體積變小、變形,細(xì)胞膜完整但出現(xiàn)發(fā)泡現(xiàn)象,細(xì)胞凋亡晚期可見凋亡小體。
貼壁細(xì)胞出現(xiàn)皺縮、變圓、脫落。
(2) 染色細(xì)胞:常用姬姆薩染色、瑞氏染色等。凋亡細(xì)胞的染色質(zhì)濃縮、邊緣化,核膜裂解、染色質(zhì)分割
成塊狀和凋亡小體等典型的凋亡形態(tài)。
生物幫上面有這方面的專業(yè)介紹, bd流流式細(xì)胞儀,流式細(xì)胞儀原理,流式細(xì)胞儀,流式細(xì)胞儀的用途
細(xì)胞活性測定方法有臺盼藍(lán)染色法、克?。洌┬纬煞ā?H 放射性同位素?fù)饺敕?、MTT 法等。
其中 MTT 法以其快速簡便,不需要特殊檢測儀器、無放射性同位素、適合大批量檢測的特點(diǎn)而得到廣泛的應(yīng)用。但 MTT 法形成的 Formazan 為水不溶性的,需要加有機(jī)溶劑溶解,由于在去上清操作時會有可能帶走小部分的 Formazan ,故有時重復(fù)性略差。
為了解決這個問題,研究人員又開發(fā)了很多種水溶性的四氮唑鹽類:如 XTT 、CCK-8 ( WST-8 )等。
聲明:本網(wǎng)站尊重并保護(hù)知識產(chǎn)權(quán),根據(jù)《信息網(wǎng)絡(luò)傳播權(quán)保護(hù)條例》,如果我們轉(zhuǎn)載的作品侵犯了您的權(quán)利,請在一個月內(nèi)通知我們,我們會及時刪除。
蜀ICP備2020033479號-4 Copyright ? 2016 學(xué)習(xí)鳥. 頁面生成時間:2.827秒